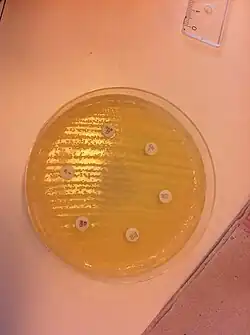

Antibiogramm
Ein Antibiogramm ist das Ergebnis eines Labortests zur Bestimmung der Empfindlichkeit bzw. Resistenz von mikrobiellen Krankheitserregern gegenüber Antibiotika. Bei dem Testverfahren wird geprüft, ob ein Bakterium durch ein Antibiotikum in einer bestimmten Konzentration im Wachstum gehemmt wird, dann ist es empfindlich (sensitiv, manchmal auch als sensibel bezeichnet) gegenüber diesem oder ob keine Wachstumshemmung erfolgt, dann ist es resistent (widerstandsfähig) gegen den Wirkstoff. Im medizinischen Fachjargon wird dieses mikrobiologische Testverfahren auch als Empfindlichkeitstestung oder Resistenztestung bezeichnet. In englischsprachigen Ländern ist der Begriff Antimicrobial Susceptibility Testing (AST) geläufig.
Medizinische Bedeutung
Ein Antibiogramm wird vor jeder Antibiotikatherapie empfohlen.[1] Die Behandlung sollte aber bei therapiebedürftigen Infektionen schon parallel zur Erstellung eines Antibiogramms erfolgen, um die erforderliche antibiotische Therapie nicht zu verzögern. Solange der Krankheitserreger noch nicht identifiziert wurde, wird eine kalkulierte Therapie begonnen, die auf Erfahrungswerten beruht. Nach Identifizierung und dem Ergebnis des Antibiogramms kann dann gegebenenfalls eine gezielte Therapie eingeleitet werden.[2][3] Das Antibiogramm ist hilfreich, da kein Antibiotikum gegen alle möglichen Krankheitserreger wirksam ist und die Gefahr der Multiresistenz bei klinisch relevanten Bakterien ein ernst zu nehmendes Problem darstellt.
Agardiffusionstest
Beim Agardiffusionstest wird – häufig nach der Kirby-Bauer-Methode – der zu untersuchende Mikroorganismus in geringer Menge auf der Oberfläche eines speziellen ebenflächigen Nährbodens verteilt und der Nährboden dann mit kreisförmigen Plättchen aus saugfähigem Material belegt, die verschiedene Antibiotika in definierter Menge enthalten. Die Antibiotika lösen sich im Gelnährboden und diffundieren radial nach außen. Je weiter das Antibiotikum vom Plättchen wegdiffundiert, desto geringer wird seine Konzentration. Bei einer bestimmten Entfernung vom Plättchen ist die Konzentration des Antibiotikums so niedrig, dass der Mikroorganismus trotz Vorhandensein des Antibiotikums wachsen kann. Nach einer Bebrütungszeit, die für eine Vermehrung der Mikroorganismen bis zum sichtbaren Bewuchs des Nährbodens ausreicht (bei pathogenen Bakterien meistens 16 bis 20 Stunden), werden die Radien der Hemmhöfe ausgemessen und hinsichtlich Resistenz oder Sensitivität des Mikroorganismus ausgewertet.[1]
Dieses Testverfahren wird auch als Plattendiffusionstest bezeichnet, da es in einer Platte, genauer in einer Petrischale durchgeführt wird.[4] Für Antibiogramme, die in großem Umfang in Laboratorien der medizinischen Mikrobiologie erstellt werden, stehen technische Hilfsmittel zur Verfügung, beispielsweise Stempel, mit denen mehrere verschiedene Antibiotikaplättchen gleichzeitig auf das Nährmedium aufgebracht werden können.
Dilutionsmethode zur Bestimmung des MHK- oder MBK-Wertes
Die Minimale Hemm-Konzentration (MHK) ist die geringste Konzentration eines Hemmstoffs, bei der die Vermehrung des Mikroorganismus noch unterbunden wird. Die minimale bakterizide Konzentration (MBK) ist im Unterschied zur minimalen Hemmkonzentration (MHK) die Konzentration, die ausreicht, um 99,9 % der Individuen des geprüften Mikroorganismus abzutöten. Diese Größen können durch den beschriebenen Agardiffusionstest nicht so exakt bestimmt werden, hierzu verwendet man einen Verdünnungstest.
Mikrodilutionsmethode

Bei der Mikrodilutionsmethode (lat. diluere, „verdünnen“) wird von dem zu untersuchenden Mikroorganismus eine Aufschwemmung in einem flüssigen Nährmedium (Bouillon) hergestellt. Zu dieser gibt man eine definierte Menge eines Antibiotikums. Wird dies mit verschiedenen Konzentrationen des Antibiotikums durchgeführt, z. B. mit einer Verdünnungsreihe (1, 2, 4, 8, 16, 32 mg/L), so kann man eine MHK-Bestimmung durchführen, welche genauer ist als die Bestimmung der Empfindlichkeit mit dem Agardiffusionstest. Die Vermehrung des Mikroorganismus ist an einer Trübung des Nährmediums zu erkennen: Bleibt es klar, so ist der untersuchte Mikroorganismus gegen dieses Antibiotikum in dieser Konzentration empfindlich (sensitiv). Die niedrigste Konzentration (höchste Verdünnung), bei der eine Hemmung erfolgt, liefert den MHK-Wert.[1][2] Von Mikrodilutionsmethode spricht man, wenn das Verfahren mit kleinen Volumina, z. B. in einer Mikrotiterplatte durchgeführt wird. Werden größere Volumina, wie in Kulturröhrchen verwendet, spricht man allgemeiner vom Bouillondilutionstest.[2]
Automatisierte Resistenzbestimmungen
Es gibt verschiedene Geräte, die eine Antibiotikaresistenz-Bestimmung durchführen. Diese Geräte arbeiten nach der Mikrodilutionsmethode mit Mikrotiterplatten. Auch das Auslesen der Messergebnisse wird von den Geräten (Plate Reader) übernommen, mit Hilfe fotometrischer Messverfahren. Die zu den Geräten gehörige Software beurteilt die Ergebnisse und prüft diese auf Plausibilität. Beispiele für derartige automatisierte Laborgeräte sind:
- VITEK von bioMérieux
- Phönix von Becton Dickinson
Auswertung
Ausgewertet wird anhand ausgewählter Normen, beispielsweise
Weitere Testverfahren
Einen Spezialfall eines Antibiogramms stellt der Epsilometertest (E-Test) dar, mit dem ebenfalls die Minimale Hemm-Konzentration bestimmt werden kann, der vom Verfahren her jedoch auf dem Agardiffusionstest beruht.
Bei der Erforschung von antibiotischen Wirkstoffen kann zur Erfassung ihres Wirkungsspektrums auf Mikroorganismen auch ein Strichtest durchgeführt werden. Hierzu wird in die Mitte der Oberfläche des Nährbodens das Antibiotikum beispielsweise auf einem Filterplättchen aufgegeben und verschiedene Indikatororganismen radial dazu ausgestrichen. Nach Inkubation lässt sich eine Hemmung daran erkennen, dass der Impfstrich nicht vollständig bis zum Antibiotikum bewachsen ist. Das Antibiotikum wirkt folglich auf den dazugehörigen Indikatororganismus, dieser ist sensitiv.[4]
Weblinks
- Antibiogramm-Hefepilze. In: Laborlexikon. Abgerufen am 12. März 2018.
Einzelnachweise
- ↑ a b c Michael T. Madigan, John M. Martinko, Jack Parker: Brock Mikrobiologie. Deutsche Übersetzung herausgegeben von Werner Goebel, 1. Auflage. Spektrum Akademischer Verlag GmbH, Heidelberg/Berlin 2000, ISBN 3-8274-0566-1, S. 966–968.
- ↑ a b c Herbert Hof, Rüdiger Dörries: Duale Reihe: Medizinische Mikrobiologie. 3. Auflage. Thieme Verlag, Stuttgart 2005, ISBN 978-3-13-125313-2, S. 11–12, 289–296.
- ↑ Marianne Abele-Horn: Antimikrobielle Therapie. Entscheidungshilfen zur Behandlung und Prophylaxe von Infektionskrankheiten. Unter Mitarbeit von Werner Heinz, Hartwig Klinker, Johann Schurz und August Stich, 2., überarbeitete und erweiterte Auflage. Peter Wiehl, Marburg 2009, ISBN 978-3-927219-14-4, S. 260–267 (Antimikrobielle Therapie spezifischer Erreger nach Antibiogramm).
- ↑ a b Hans G. Schlegel, Christiane Zaborosch: Allgemeine Mikrobiologie. 7. Auflage. Thieme Verlag, Stuttgart/New York 1992, ISBN 3-13-444607-3, S. 364–367.